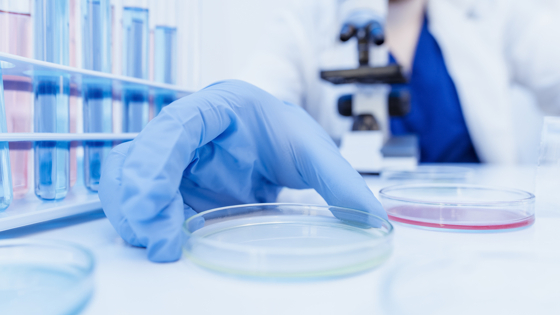

У штамма "омикрон" появился подвид
Ученые нашли новый подвид омикрон-штамма коронавируса. Об этом сообщает The Guardian со ссылкой на министра здравоохранения Квинсленда Иветт Д'Ат.
Он был обнаружен у австралийца в штате Квинсленд, который вернулся из Нигерии. Пока известно лишь то, что его тяжело диагностировать с помощью ПЦР-теста.
"Я хочу выразить огромную благодарность нашим судебно-медицинским и научным службам, потому что их работа с международным комитетом привела к переклассификации "омикрона" на два подвида, и оба они есть здесь, в Квинсленде", — отметила министр.
Врач-инфекционист и микробиолог из Австралийского национального университета профессор Питер Коллиньон уверен, что этот подвид "омикрона" уже распространяется по разным странам. Однако называть его новым штаммом нельзя.
"Не думаю, что это можно назвать новым вариантом, это подтип. Новый вариант означает серьезное изменение по сравнению с теми штаммами, которые у нас уже были"
Пока что о новом штамме появляется двоякая информация. Известно, что он имеет высокую скорость распространения. Иммунолог назвал опасное заблуждение о штамме "омикрон".